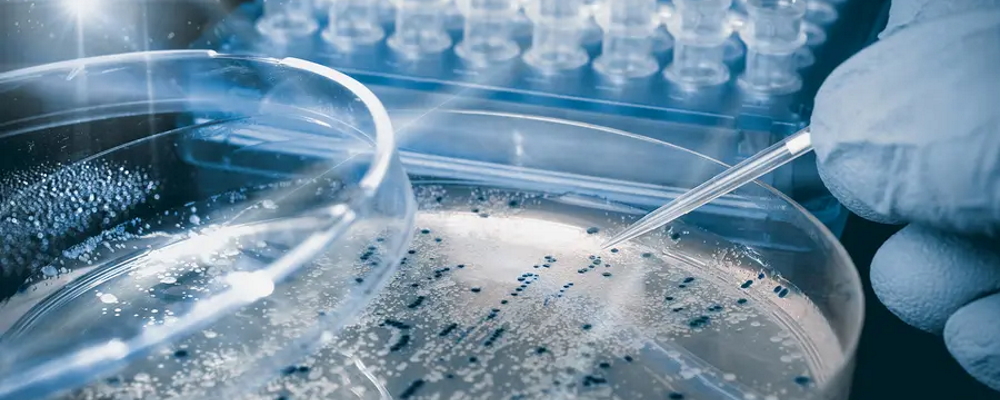
Teste de sanitație pentru personal, suprafețe de lucru, echipamente.

Consaltis Consultanță și Audit vă ofere servicii complete la nivel național de consiliere în vederea implementării și menținerii unui sistem de siguranța alimentului bazat pe principiile HACCP și a standardului ISO 22000. De asemenea, vă putem asista în timpul controalelor din partea DSVSA sau la obținerea diverselor autorizații necesare.
Serviciile noastre sunt oferite sub formă punctuală sau pe baza unor abonamente lunare/trimestriale/semestriale la prețuri accesibile.
Vă putem consilia în echiparea unităților de alimentație publică - restaurant, catering, fast-food - ajutându-vă la obținerea unor prețuri foarte bune la echipamente și utilaje de la partenerii noștri.


Consultanță
Activitatea noastră își propune să vă ajute în implementarea unui sistem de siguranța alimentului bazat pe principiile HACCP.
Detalii...
Audit
Auditul reprezintă o formă de asigurare că o organizație respectă reglementările interne și externe, oferind o opinie independentă, prin care părțile interesate pot obține o imagine clară asupra performanțelor. Specialiștii noștri au o abordare bazată pe riscuri în evaluarea eficienței operaționale a clientului, sistemelor și controalelor pe domeniile auditate.
Detalii...
Instruirea
Instruirea ajută un angajat să fie mai eficient pe un post. Ea aduce beneficii numai dacă modul de livrare și conținutul se concentrează asupra acelor competențe (cunoștințe, abilități și atitudini) necesare îmbunătățirii performanței postului. Cu alte cuvinte, training-ul este eficace (produce rezultate), atunci când răspunde, în egală măsură, nevoilor organizației și ale angajatului.
Detalii...